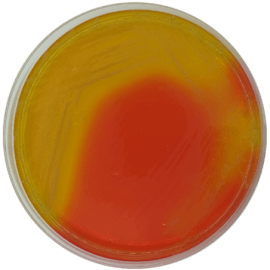
main product photo

Close
Burkholderia cepacia Selective Agar Base USP 500 grams/bottle
SKU
CDL/2201
Brand
CONDALAB
Pre-order (Deliver in 8 to 12 weeks)
Burkholderia Cepacia Selective Agar Base is a medium used to test the presence or absence of Burkholderia cepacia complex (Bcc) in non-sterile pharmaceutical and cosmetic products.
Burkholderia cepacia complex (Bcc) is a group of 17 closely related bacteria species. Bcc are Gram-negative aerobic bacteria that can be found in water and soil. Water is the most common raw material used in pharmaceutical formulations, so Bcc can contaminate these preparations.
The USP recommends this medium to ensure the absence of Bcc in regulated products. Bcc are opportunistic pathogens and can pose serious medical risks to populations susceptible to infections such as elderly people and children, as well as to immunocompromised populations such as those with cystic fibrosis, cancer and AIDS.
The possible presence of Bcc is indicated by the growth of greenishbrown colonies with yellow halos, or white colonies surrounded by a pinkred zone on BCSA. Any growth on BCSA is confirmed by identification tests.
Burkholderia Cepacia Selective Agar Base is a medium used to test the presence or absence of Burkholderia cepacia complex (Bcc) in non-sterile pharmaceutical and cosmetic products.
Burkholderia cepacia complex (Bcc) is a group of 17 closely related bacteria species. Bcc are Gram-negative aerobic bacteria that can be found in water and soil. Water is the most common raw material used in pharmaceutical formulations, so Bcc can contaminate these preparations.
The USP recommends this medium to ensure the absence of Bcc in regulated products. Bcc are opportunistic pathogens and can pose serious medical risks to populations susceptible to infections such as elderly people and children, as well as to immunocompromised populations such as those with cystic fibrosis, cancer and AIDS.
The possible presence of Bcc is indicated by the growth of greenishbrown colonies with yellow halos, or white colonies surrounded by a pinkred zone on BCSA. Any growth on BCSA is confirmed by identification tests.
| Brand | CONDALAB |
|---|
Write Your Own Review

Validate your login